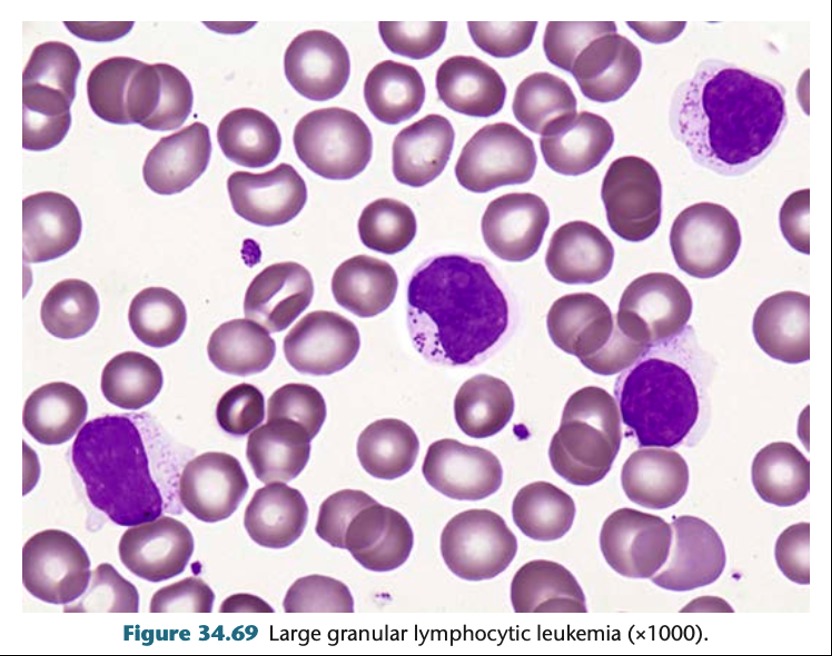
5331027-6261f96e57df4.jpg

35. 一位45歲女性的週邊血液白血球高達21,000/µL,其中淋巴球占了65%,大部分的型態如下 圖所示,此血球最有可能是下列何者?
(A)small lymphocyte
(B)large granular lymphocyte
(C)lymphoblast
(D)plasma cell
答案:登入後查看
統計: A(193), B(1434), C(267), D(171), E(0) #1150969
統計: A(193), B(1434), C(267), D(171), E(0) #1150969
詳解 (共 3 筆)
#5331027
Large Granular Lymphocyte Leukemia
This is a clonal proliferation of CD3(+) cytotoxic T-lymphocytes,
The median age is 63 years and 60% to 70% of patients are symptomatic with recur- rent infections due to neutropenia
參考資料:血液國考用書
Henrys Clinical Diagnosis and Management
5
0